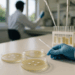
La BUAP desarrolla inhibidores de bacterias

En el ámbito de la investigación de mercado, el avance tecnológico ha abierto nuevas puertas para las empresas que buscan entender la satisfacción del cliente de manera más eficiente y económica. Durante años, las compañías de la lista Fortune 500 dependieron de firmas de investigación de mercado, un proceso costoso y prolongado, con un alto precio por las valiosas percepciones obtenidas.
En este contexto, surge Keplar, una startup innovadora que ha transformado el panorama con su enfoque de investigación a través de inteligencia artificial de voz. Desde su reciente recaudación de 3.4 millones de dólares en fondos iniciales, liderada por Kleiner Perkins y respaldada por SV Angel, Common Metal y South Park Commons, ha comenzado a marcar la diferencia en la forma en que las empresas recopilan datos sobre los clientes. Su fundación se remonta a 2023, cuando Dhruv Guliani y William Wen idearon este concepto mientras participaban en un programa de becas para fundadores.
Los creadores de Keplar dialogaron con profesionales del sector y descubrieron que los métodos tradicionales—basados en encuestas escritas e entrevistas humanas—podrían ser revolucionados por la inteligencia artificial conversacional. Esta herramienta permite a los negocios configurar estudias en cuestión de minutos. La plataforma de la startup convierte cualquier consulta sobre un producto en una guía para moderar entrevistas, facilitando la recolección de información de los consumidores sobre sus preferencias y aversiones.
Mediante acceso a los sistemas CRM de los clientes, el asistente de voz de Keplar se comunica directamente con consumidores existentes, facilitando un análisis interno que se presenta en informes y presentaciones de PowerPoint que imitan el formato de los entregables tradicionales. Cabe destacar que los avances en los modelos de lenguaje han elevado la calidad de esta tecnología, haciendo que los participantes en algunos casos no se percaten de que interactúan con un asistente algorítmico.
Los usuarios de esta innovadora plataforma incluyen nombres reconocidos, como Clorox e Intercom, resaltando la creciente aceptación de esta nueva modalidad de investigación. Sin embargo, Keplar no está sola en este campo disruptivo; competidores relevantes como Outset y Listen Labs también están innovando en este sector, cada uno atrayendo inversiones significativas.
Con el continuo desarrollo y la evolución de la inteligencia artificial, el futuro de la investigación de mercado se avizora más dinámico y accesible, adaptándose a las necesidades emergentes del ámbito empresarial y ofreciendo un enfoque más inmediato y efectivo para captar la voz del consumidor. Este cambio radical está, sin duda, destinado a transformar el estándar de la industria en los años venideros.
Gracias por leer Columna Digital, puedes seguirnos en Facebook, Twitter, Instagram o visitar nuestra página oficial. No olvides comentar sobre este articulo directamente en la parte inferior de esta página, tu comentario es muy importante para nuestra área de redacción y nuestros lectores.